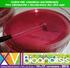
SOCIEDAD VENEZOLANA DE BIOANALISTAS ESPECIALISTAS PROGRAMA DIPLOMADO BACTERIOLOGÍA CLÍNICA (II Edición: Mayo-Agosto 2013) OBJETIVO DURACIÓN

INFECCIONES HOSPITALARIAS
|
|
|
- María Isabel Mendoza Quintana
- hace 9 años
- Vistas:
Transcripción
1 INFECCIONES HOSPITALARIAS Julio C. Blanco Toloza INTRODUCCION " Puede existir mayor contradicción que adquirir una enfermedad en el Hospital?" (Peter Frank, profesor de Medicina, U.K.). La Infección Hospitalaria (I.H.) es aquella infección que no está presente clínicamente ni en período de incubación cuando el paciente ingresa al centro hospitalario. Habitualmente aparece más allá de las 72 hs del ingreso, dependiendo del tipo de infección. Para reconocer en cierta medida si la infección fue adquirida en la comunidad o en el hospital es imprescindible conocer el período de incubación de la enfermedad específica. Existen infecciones, como por ejemplo las de heridas quirúrgicas y las transmisibles por la sangre (Hepatitis B), que pueden aparecer luego del alta hospitalaria, y estas las debemos considerar como I.H. En 1847 K.Ignaz Semmelwieis, médico húngaro, radicado en Viena, por primera vez destaca la importancia de la transmisión infecciosa intrahospitalaria de persona a persona de la fiebre puerperal, promoviendo como medida eficaz para el control de la misma el lavado de manos. Semmelwieis observó que la principal causa de fiebre puerperal era la exploración de las pacientes por estudiantes de Medicina cuyas manos estaban impregnadas de restos de las necropsias de las pacientes, muchas de las cuales habían muerto por esta misma enfermedad. Instituyendo el lavado de manos con una solución de hipoclorito de calcio, disminuyó notablemente el número de infecciones y su mortalidad consecuente. Muchas son las causas que contribuyen en la patología infecciosa hospitalaria, pasaremos a enumerarlas: a. los microorganismos (virulencia de las cepas, patogenicidad de las especies, resistencia múltiple y número); b. el paciente y su susceptibilidad (edad, sexo, enfermedad subyacente, mecanismos de defensa y respuesta inmune); c. el medio ambiente (planta física, personal hospitalario, las visitas), y d. el tratamiento (terapia inmunodepresiva, antimicrobianos, técnicas invasivas). Estas variables además de incidir en la magnitud de la I.H. también contribuyen a la aparición de la patología infecciosa por agentes oportunistas, caracterizada por ser infecciones causadas por microorganismos de baja virulencia y no ser patógenos en huéspedes inmunocompetentes. La incidencia y la gravedad de la I.H. son mayores en los países en vía de desarrollo, por carecer de sistemas capaces de controlar este problema. Es oportuno aclarar que no todas las I.H. son prevenibles, y se estima que, como mínimo, la mitad se produciría a pesar de la aplicación de estrictas medidas de prevención recomendadas. EPIDEMIOLOGIA La infección es el resultado de la interacción entre un agente infeccioso y un huésped susceptible, dicha interacción se produce a través de un mecanismo de transmisión (éstos son los eslabones de la cadena epidemiológica). Estos huéspedes tienen factores predisponentes como la enfermedad de base y los tratamientos medicamentosos. Conociendo el principio de lo que es una infección, del punto de vista del control de la misma se deberá actuar sobre el punto más fácil de incidir, y es por ello que se actúa generalmente primero en la TRANSMISION, sin olvidarnos de los otros dos como el disminuir los RESERVORIOS de los agentes y protegiendo al HUESPED para que sea menos vulnerable. Los agentes etiológicos de I.H. pueden ser bacterias, virus, hongos y parásitos. La mayor parte son debidas a bacterias o virus, le siguen los hongos y, raramente, los parásitos. Entendemos por reservorio al lugar donde se mantiene el microorganismo con metabolismo activo y con capacidad de multiplicación, y fuente al sitio desde el que el agente infeccioso pasa al huésped. El reservorio y la fuente pueden ser lo mismo o ser diferentes (destacamos que la flora microbiana hospitalaria se caracteriza por: 1. tener perfiles de multirresistencia a los antimicrobianos y algunos antisépticos; 2. floras basales de pacientes internados alteradas por el uso de antibióticos; 3. ambientes potencialmente contaminados por los mismos pacientes o por el personal sanitario que no cumple las medidas de control de la I.H. El reservorio de los virus es generalmente el humano, mientras el de las bacterias puede ser humano, inanimado o animal. En cuanto a la transmisión, esta se puede realizar por cuatro vías: a. por contacto (directo, indirecto o por gotitas). De aquí la importancia del correcto lavado de manos 1
2 entre paciente y paciente examinado; b. por un vehículo apropiado (por ej.: alimento, solución intravenosa, dispositivos biomédicos, catéteres utilizados en procedimientos invasivos); c. por vía aerógena; y d. a través de un vector (siendo estos dos últimos excepcionales). Además del modelo de infección exógena, al que hemos hecho referencia, encontramos la infección de origen endógeno, entendiéndose por tal aquella infección a punto de partida de la flora indígena del paciente. No siempre es posible determinar con certeza si un agente infeccioso es de origen endógeno o exógeno, por ello, generalmente en vez de hablar de infección endógena se habla de infección autógena, entendiéndose por tal la infección que deriva de la flora del paciente sin especificar si el germen causal formaba parte de su flora microbiana antes del ingreso al hospital o si este se incorporó al paciente en el curso de su internación. Conocer con certeza las cepas estrictamente nosocomiales sólo es posible contando con un Departamento de Microbiología que aplique técnicas de correcta identificación taxonómica, antibiotipia, fagotipia, perfil plasmídico, etc. En los últimos 10 años se ha adelantado mucho en la investigación sobre el control de las infecciones, el desarrollo de nuevos métodos diagnósticos en base a técnicas de Biología Molecular ha permitido conocer nuevos gérmenes, mecanismos de resistencia, estudio de epidemias y de agentes infecciosos que están teniendo importancia a nivel intrahospitalario, como los virus y los hongos. El futuro de la epidemiología intrahospitalaria estará enfocado sobre dos aspectos en el control de infecciones, uno será la protección al paciente y el otro la protección al trabajador de la salud. INCIDENCIA Es difícil determinar la incidencia de la I.H. porque esta va a estar determinada en cierta medida por el tipo de servicios que presente el nosocomio y, además, si se aplican medidas de control para la infección. La veremos aumentada en aquellos servicios como Oncología, Trasplantados, Unidad de tratamiento intensivo y Cirugía, y va a estar descendida en servicios como Medicina, obstetricia y pediatría. La incidencia, en general, varía entre el 2 al 25% de los pacientes internados, dependiendo de la complejidad de los Servicios y atenciones que se presten. La incidencia también se encuentra condicionada y está aumentada en hospitales docentes. TIPOS DE INFECCION Las infecciones del tracto urinario, heridas quirúrgicas y respiratorias, constituyen cerca del 70% de la I.H. El uso de catéter vesical incide directamente en la infección urinaria, aquellos Servicios que abusen de su uso, no utilicen circuitos cerrados de recolección, y su colocación no se realice en condiciones de asepsia, tienen altas tasas de infección. La tasa de infección respiratoria aumenta con la intubación, y bajo la asistencia respiratoria mecánica. Las infecciones a nivel de heridas quirúrgicas, son el resultado de: 1. ausencia del mecanismo de barrera que ofrece la piel con la consecuencia de colonización-infección de la flora bacteriana cutánea; 2. tipo de cirugía (limpia, potencialmente contaminada o infectada); y 3. manejo de las curaciones por el personal de enfermería, entre otras. AGENTES INFECCIOSOS INVOLUCRADOS Las infecciones más frecuentes son las bacterianas, a expensas de los bacilos Gram negativos (Enterobacteriaceae y bacilos Gram negativos no fermentadores) seguidas por los cocos Gram positivos (Staphylococcus aureus, Streptococcus, Enterococcus y Staphylococcus coagulasa negativos). Escherichia coli es el patógeno más frecuente en infección urinaria, Staphylococcus aureus en las infecciones de heridas quirúrgicas, cutáneas, y en bacteriemias primarias. La flora hospitalaria se encuentra en continuo cambio, seleccionando nuevas cepas cada vez más resistentes a los antimicrobianos; ya se han aislado Enterococcus multiresistentes con resistencia incluso a Vancomicina, lo que implica la imposibilidad de tratamiento antimicrobiano alguno. Los virus son otros agentes involucrados. Es fundamental, por lo tanto, la disponibilidad de un laboratorio de diagnóstico virológico. Algunos estudios hablaban de que 1 por pacientes internados desarrolla una infección viral hospitalaria, esto se demostró que no era así, ya que dada la complejidad del diagnóstico se subvaloraba esta infección. Valenti y col. demostraron que las infecciones virales llegan a un poco más del 5% de las I.H., correspondiendo el resto a infecciones bacterianas. La epidemiología de estos dos tipos de patógenos difiere sustancialmente, los patógenos virales afectan al tracto respiratorio y gastrointestinal en un 80% aproximadamente, mientras que la infección bacteriana se encuentra cercana al 16%. En cuanto a la población de susceptibles, también se diferencia, en los pacientes pediátricos las infecciones causadas por virus se aproximan, sin superar, a las causadas por bacterias, siendo estas últimas más 2
3 prevalentes en la población adulta internada. Varios son los virus asociados con I.H. como Respivirus (influenza, Sinsicial Respiratorio, Parainfluenza), Rotavirus, Hepatitis A, Hepatitis B, Hepatitis no A no B, Herpesvirus (Citomegalovius, Varicela zoster, Herpes simple). La fuente de la infección puede ser el paciente internado, el personal sanitario y los derivados sanguíneos. Los hongos ocupan el tercer lugar como agentes patógenos en las I.H., el género más involucrado es Cándida (80%). CONSECUENCIAS DE LA I.H. Una de las principales consecuencias directas de la I.H. es la prolongación de los días de internación, como mínimo, la estadía se prolonga de 1 a 5 días, dependiendo del sitio que asienta la infección y del estado inmunitario del paciente. Aumenta los costos, promedialmente, una i, una infección implica entre U$ 600 a 700 por atención al paciente, alcanzándose cifras a veces muy superiores a estas dependiendo del costo del o los antimicrobianos utilizados y de la localización de la infección. Las localizaciones más costosas son las infecciones respiratorias bajas, bacteriemias e infecciones de heridas quirúrgicas. Aumenta la mortalidad, generalmente el 1% de las I.H. es la causa de muerte del paciente y cerca del 3% contribuye a la muerte. La Neumonía hospitalaria es, generalmente, la principal causal de muerte seguida por Bacteriemia primaria y Meningitis. También, en cuanto a consecuencias económicas ocasionadas por las I.H., encontramos cada vez con mayor impacto las demandas civiles y penales realizada por los mismos pacientes, sus familiares y el personal sanitario. DIAGNOSTICO DE LA I.H. La historia clínica cuidadosa, el examen físico minucioso y la evolución clínica siguen siendo los pilares del diagnóstico clínico orientador del estudio microbiológico. Los procedimientos diagnósticos empleados suponen la demostración directa de la presencia del agente causal de infección o bien técnicas indirectas (serología). Esto condiciona naturalmente que el nosocomio cuente con un laboratorio de Microbiología, capaz de realizar cultivos, correcta identificación taxonómica, test de susceptibilidad antimicrobiana, serología, etc. La aparición de la patología infecciosa oportunista, microorganismos multiresistentes a los antimicrobianos, la baja expresividad de las infecciones en pacientes inmunodeprimidos y la incidencia cada vez más elevada de infecciones endógenas en pacientes con patología múltiple, determina la complejidad del diagnóstico y la difícil aplicabilidad de protocolos establecidos, determinando en cierta forma la individualidad para cada caso. A veces lo difícil de lograr una buena toma bacteriológica como su correcta interpretación determina el uso de técnicas diagnósticas aun más agresivas como: punción aspirativa pulmonar, biopsia hepática, etc. VIGILANCIA, CONTROL Y PREVENCION DE LA I.H. En 1968 se publica en Inglaterra un manual o monografía titulado "Infection Control in the Hospital" de la Asociación Americana de Hospitales, conteniendo normas mínimas para el control de las infecciones en los pacientes; este manual sugería la necesidad de la creación del Comité de Infecciones, siendo este el centro de las decisiones y el cuerpo estratégico para el control de las infecciones. Algunas de esas normas eran: 1. formar un servicio de vigilancia, 2. características en cuanto planta física, 3. facilidades para el aislamiento de pacientes infectados, 4. un competente Departamento de Microbiología, 5. enfermería exclusiva para el área de obstetricia, y 6. medidas apropiadas contra la contaminación de alimentos entre otras. En 1970 datos subsecuentes derivados del SENIC (Estudio de la Eficacia del Control de Infecciones Hospitalarias, Programa SENIC, llevado a cabo por el CDC), demostraban la carencia en cuanto a conocimiento en el control de infecciones. Menos del 10% de los hospitales habían establecido la posición del profesional de enfermería en el control de infecciones, no más del 10% de ellos había puesto en práctica la política del cambio de catéteres cada 72 horas, menos del 10% habían adoptado sistemas de drenaje urinario cerrado, y cerca del 10% tenían normatizado el cambio de tubos de ventilación como mínimo cada 24 horas. Cada 10 años, a partir de 1970, el CDC (Centro de Control de Enfermedades) ha realizado una conferencia internacional de I.H. en Atlanta (Georgia, USA). En 1980 se realizó la 2ª conferencia, destacando algunos avances en cuanto a número de instituciones que habían adoptado programas de vigilancia y control; y que muchos expertos profesionales médicos, de enfermería y de otras áreas de la salud dedicaban parte considerable de su tiempo, si no todo, a las infecciones nosocomiales. Los miembros de dicha comisión deberán ser representantes interesados e influyentes de los principales Departamentos del Hospital, incluyendo 3
4 Microbiología, Cirugía, Medicina, Enfermería, Farmacia, Administración, además de contar con personal operativo que suministre los datos de la vigilancia e información técnica a la Comisión. La función básica de esta Comisión es establecer políticas generales para el control de las infecciones en el hospital. Este cometido es posible: a. estableciendo un sistema de información y archivo que permita conocer el tipo y frecuencia de infección entre todas las personas del complejo hospitalario, b. manteniendo al Departamento de Microbiología continuamente informado y conseguir que se practiquen aquellos métodos y técnicas que hagan posible el control de la infección, c. revisando periódicamente las técnicas de asepsia utilizadas en áreas críticas del nosocomio (quirófanos, C.T.I., etc.), d. intentando reducir el uso de antimicrobianos, tanto en el tratamiento como en la profilaxis, y e. creando un programa educacional dirigido a todo el personal del Hospital destinado a conocer la importancia y peligros de la I.H., así como las medidas a adoptar para combatirla. Las medidas preventivas, como habíamos hablado al comienzo del capítulo, era actuar a nivel de la fuente y/o reservorio, la transmisión y el huésped susceptible. Es, sin lugar a dudas, a nivel de la transmisión donde se actúa con mayor efectividad. Prodigar el lavado de manos antes y después del contacto con los pacientes ha descendido en forma categórica la incidencia de la infección exógena (llamada también infección cruzada) y aislando al paciente ya infectado. Es decir, se trata de crear una barrera aséptica en torno al paciente infectado y esto es lo que se conoce como medidas de aislamiento. Podemos plantear cuatro tipos de aislamientos: estricto (Difteria, Peste, Rabia), entérico (Cólera, Fiebre tifoidea, Gastroenteritis), respiratorio (Sarampión, Tos Convulsa, Tuberculosis pulmonar, Meningitis meningocóccica) y de contacto (Impétigo, Gangrena gaseosa). Dependiendo de estos tipos serán imprescindibles el lavado de manos antes y después del examen clínico (esto siempre), guantes, mascarillas y sobretúnicas. Podemos incluir un quinto tipo de aislamiento que es el "preventivo", en este caso el objetivo ya no es impedir que la infección se disemine sino proteger a un paciente de la colonización y posterior infección por gérmenes hospitalarios, del personal sanitario y de los visitantes. Se aplica a aquellos pacientes inmunodeprimidos (Agamaglobulinemias, quemados, transplantados, granulocitopenias en general). Es preciso señalar que este tipo de aislamientos no los protegerá contra las infecciones endógenas causadas por su propia flora microbiana. En este sentido la administración de antimicrobianos, medidas rigurosas de higiene cutánea y de alimentación especialmente preparada, parecen contribuir de modo eficaz a descender la incidencia por este tipo de infección. PAPEL DEL LABORATORIO DE MICROBIOLOGIA Son numerosas las funciones que cumple dicho departamento en la vigilancia, control y prevención de la I.H. Enumeraremos algunas de ellas sin entrar en detalle, estas son: a. participación con un miembro activo a nivel del Comité de Infecciones, b. actividad docente del punto de vista de los aspectos microbiológicos de las I.H. al personal que las controla, c. diagnóstico etiológico de la infección en base a una correcta identificación taxonómica y caracterización de cepas en base a fagotipia, antibiotipia, perfil plasmídico y técnicas de biología molecular, d. apoyo en las investigaciones de los problemas específicos de la infección hospitalaria como la investigación de un brote infeccioso, orientación terapéutica antimicrobiana más conveniente para el paciente conociendo la sensibilidad del agente, e. control de técnicas de esterilización y desinfección en forma rutinaria, y en contadas situaciones, control del personal sanitario y del ambiente. BIBLIOGRAFIA 1. Center for Disease Control. Natural nosocomial infection study report. Annual Summary, 1979, Atalta, Dubay, E.; Grubb, R. Infecciones Hospitalarias, prevención y control. Bs. As., Panamericana, Finegold, S.M.; Ellen, Y.; Baron, D. Hospital Epidemiology in Diagnostic Microbiology. Bailey, B. and Scott, Chicago, University. 1986: Infecciones Hospitalarias. Gustavo Malagón- Lodoño, M.D., Liboardo Hernández Esquivel, Q.F. 1ª ed., Bogotá D.C. Editorial Médica Panamericana, Lennette, B.H.; Ballows, A.; Hauler, W.Y. Manual of clinical Microbiology. 5º Ed. American Society for Microbiology, Lossa, G.R.; Valzacchi, R. Estimación del costo de las infecciones hospitalarias. Bol. O.P.S : National Nosocomial Infections Surveillance System (NNIS), Nosocomial Infection rates for interhospital comparision, limitation and possible solutions. Infect. Control. Hosp. Epidemol : Prevention and Control of Nosocomial Infectios. 2ª Edition, Edited by Richard P. Wnzel, M.D., M.S.C., William & Wilkins, Reunión Latinoamericana sobre Programas de Control de Infecciones Hospitalarias, recomendaciones. 4
5 Caracas, Actual. Infect : World Health Organization. Protocol for an International Survey of the Prevalence of Nosocomial Infection Geneve,
Manual de control de infecciones y epidemiología hospitalaria
 Manual de control de infecciones y epidemiología hospitalaria Silvia I. Acosta-Gnass ManualControldeInfecciones.indd 1 Organización Panamericana de la Salud. Manual de control de infecciones y epidemiología
Manual de control de infecciones y epidemiología hospitalaria Silvia I. Acosta-Gnass ManualControldeInfecciones.indd 1 Organización Panamericana de la Salud. Manual de control de infecciones y epidemiología
LA HIGIENE DE MANOS NO ES UN CONCEPTO NUEVO
 Lic. Roxana Carranza Coronel DICIEMBRE 2014 LA HIGIENE DE MANOS NO ES UN CONCEPTO NUEVO 1861, Iganz Phillip Semmelweis impuso como practica sanitaria el lavado de manos antes y después de la atención de
Lic. Roxana Carranza Coronel DICIEMBRE 2014 LA HIGIENE DE MANOS NO ES UN CONCEPTO NUEVO 1861, Iganz Phillip Semmelweis impuso como practica sanitaria el lavado de manos antes y después de la atención de
Índice PATOGENIA Y PREVENCIÓN DE LA INFECCIÓN QUIRÚRGICA. Capítulo 1 Conceptos de microbiología aplicada
 Índice SECCIÓN I: PATOGENIA Y PREVENCIÓN DE LA INFECCIÓN QUIRÚRGICA Capítulo 1 Conceptos de microbiología aplicada Introducción.............................................. 28 Factores predisponentes
Índice SECCIÓN I: PATOGENIA Y PREVENCIÓN DE LA INFECCIÓN QUIRÚRGICA Capítulo 1 Conceptos de microbiología aplicada Introducción.............................................. 28 Factores predisponentes
Elementos básicos de los programas de prevención de infecciones asociadas a la atención en salud (PCI)
 Elementos básicos de los programas de prevención de infecciones asociadas a la atención en salud (PCI) Dr Fernando Otaíza O Ryan MSc Depto calidad y Seguridad del Paciente MINSAL Presentación Normativas
Elementos básicos de los programas de prevención de infecciones asociadas a la atención en salud (PCI) Dr Fernando Otaíza O Ryan MSc Depto calidad y Seguridad del Paciente MINSAL Presentación Normativas
FLORA NORMAL. ORAL Y T.R.A. Streptococcus spp. Número de bacterias por g de tejido o líquido o por cm 2 de superficie de piel
 FLORA NORMAL Número de bacterias por g de tejido o líquido o por cm 2 de superficie de piel PIEL Staphylococcus epidermidis Staphylococcus aureus Micrococcus luteus Corynebacterium spp. ORAL Y T.R.A. Streptococcus
FLORA NORMAL Número de bacterias por g de tejido o líquido o por cm 2 de superficie de piel PIEL Staphylococcus epidermidis Staphylococcus aureus Micrococcus luteus Corynebacterium spp. ORAL Y T.R.A. Streptococcus
La flora de las manos
 La flora de las manos Flora normal o residente Frecuentemente aislados de la piel Son residentes permanentes No se pueden remover fácilmente Viven en la parte superficial del estrato córneo Se multiplican
La flora de las manos Flora normal o residente Frecuentemente aislados de la piel Son residentes permanentes No se pueden remover fácilmente Viven en la parte superficial del estrato córneo Se multiplican
Erika Miranda G. Enfermera UPC MQ HCUC. Junio 2013
 Erika Miranda G. Enfermera UPC MQ HCUC Junio 2013 Son las infecciones que aparece 48 a 72 horas luego de recibir atención de salud ambulatoria o de hospitalización, y que no estaban presentes ni en incubación
Erika Miranda G. Enfermera UPC MQ HCUC Junio 2013 Son las infecciones que aparece 48 a 72 horas luego de recibir atención de salud ambulatoria o de hospitalización, y que no estaban presentes ni en incubación
CRECER CAPACITACIÓN INFECCIONES ASOCIADAS A LA ATENCIÓN DE SALUD 80 HORAS
 INFECCIONES ASOCIADAS A LA ATENCIÓN DE SALUD 80 HORAS www.crecercapacitacion.cl 56228807830 DESTINARIOS: Personal de Instituciones de salud públicas y privadas Objetivos Generales Adquirir competencias
INFECCIONES ASOCIADAS A LA ATENCIÓN DE SALUD 80 HORAS www.crecercapacitacion.cl 56228807830 DESTINARIOS: Personal de Instituciones de salud públicas y privadas Objetivos Generales Adquirir competencias
INFECCIÓN NOSOCOMIAL: ESTÁ EN TUS MANOS
 INFECCIÓN NOSOCOMIAL: ESTÁ EN TUS MANOS Imagino que todos sabréis a lo que me refiero cuando hablo de infección nosocomial, pero por si alguien desconociera este concepto, vamos a ver de qué se trata antes
INFECCIÓN NOSOCOMIAL: ESTÁ EN TUS MANOS Imagino que todos sabréis a lo que me refiero cuando hablo de infección nosocomial, pero por si alguien desconociera este concepto, vamos a ver de qué se trata antes
Microorganismos multiresistentes y su transmisión. Dra. Dona Benadof Microbiología, Unidad de IIH
 Microorganismos multiresistentes y su transmisión Dra. Dona Benadof Microbiología, Unidad de IIH Microorganismos multiresistentes Son microorganismos resistentes ( MOMR) a múltiples antibióticos Por definición
Microorganismos multiresistentes y su transmisión Dra. Dona Benadof Microbiología, Unidad de IIH Microorganismos multiresistentes Son microorganismos resistentes ( MOMR) a múltiples antibióticos Por definición
Prevención y Control de Infecciones Intrahospitalarias. Dr. Martin Yagui Moscoso
 Prevención y Control de Infecciones Intrahospitalarias Dr. Martin Yagui Moscoso Contenido Definiciones Antecedentes de importancia Áreas de acción ( Qué temas incluye?) Aislamiento hospitalario (precauciones
Prevención y Control de Infecciones Intrahospitalarias Dr. Martin Yagui Moscoso Contenido Definiciones Antecedentes de importancia Áreas de acción ( Qué temas incluye?) Aislamiento hospitalario (precauciones
Universidad de Cantabria INFECCIÓN NOSOCOMIAL
 Universidad de Cantabria INFECCIÓN NOSOCOMIAL ESQUEMA GENERAL Introducción: Concepto e Importancia sanitaria. Cadena epidemiológica. Sistemas de vigilancia. Principales tipos de infección nosocomial. Prevención
Universidad de Cantabria INFECCIÓN NOSOCOMIAL ESQUEMA GENERAL Introducción: Concepto e Importancia sanitaria. Cadena epidemiológica. Sistemas de vigilancia. Principales tipos de infección nosocomial. Prevención
Norma de Manejo de Brote Epidémico
 Página 1 de 7 Página 2 de 7 4. Definiciones: 4.1 Brote: Aumento inusitado, significativo de la incidencia de una determinada enfermedad en un período de tiempo, en una sola población o grupo de la población,
Página 1 de 7 Página 2 de 7 4. Definiciones: 4.1 Brote: Aumento inusitado, significativo de la incidencia de una determinada enfermedad en un período de tiempo, en una sola población o grupo de la población,
3.- Higiene de manos y Antisepsia cutánea
 Higiene de manos La medida más sencilla y eficaz para reducir la infección asociada a la asistencia sanitaria Transmisión cruzada de microorganismos a través de las manos: Las manos de los profesionales
Higiene de manos La medida más sencilla y eficaz para reducir la infección asociada a la asistencia sanitaria Transmisión cruzada de microorganismos a través de las manos: Las manos de los profesionales
RIESGO DE INFECCIONES OCUPACIONALES EN EL PERSONAL DE SALUD
 RIESGO DE INFECCIONES OCUPACIONALES EN EL PERSONAL DE SALUD COMISIÓN PARA EL ESTUDIO DEL IMPACTO PSICOSOCIAL DEL VIH-SIDA Y OTRAS ENFERMEDADES EMERGENTES. SMU RIESGO DEL PERSONAL DE SALUD DE PADECER INFECCIONES!
RIESGO DE INFECCIONES OCUPACIONALES EN EL PERSONAL DE SALUD COMISIÓN PARA EL ESTUDIO DEL IMPACTO PSICOSOCIAL DEL VIH-SIDA Y OTRAS ENFERMEDADES EMERGENTES. SMU RIESGO DEL PERSONAL DE SALUD DE PADECER INFECCIONES!
"MASTER EN ENFERMEDADES INFECCIOSAS DEL PACIENTE INMUNODEPRIMIDO"
 "MASTER EN ENFERMEDADES INFECCIOSAS DEL PACIENTE INMUNODEPRIMIDO" Universidad Complutense de Madrid Vicerrectorado de Tercer Ciclo y Formación Continuada Director del Master Prof. José María Aguado Catedrático
"MASTER EN ENFERMEDADES INFECCIOSAS DEL PACIENTE INMUNODEPRIMIDO" Universidad Complutense de Madrid Vicerrectorado de Tercer Ciclo y Formación Continuada Director del Master Prof. José María Aguado Catedrático
Prevención y Control de Infecciones Intrahospitalarias. Dr. Martin Yagui Moscoso
 Prevención y Control de Infecciones Intrahospitalarias Dr. Martin Yagui Moscoso Contenido Definiciones Antecedentes de importancia Áreas de acción ( Qué temas incluye?) Aislamiento hospitalario (precauciones
Prevención y Control de Infecciones Intrahospitalarias Dr. Martin Yagui Moscoso Contenido Definiciones Antecedentes de importancia Áreas de acción ( Qué temas incluye?) Aislamiento hospitalario (precauciones
Control de Procesos en Infección Asociada a la Asistencia Sanitaria
 Control de Procesos en Infección Asociada a la Asistencia Sanitaria David Cantero González Subdirección de Calidad Organización Central de Osakidetza Infección asociada a la asistencia sanitaria Evento
Control de Procesos en Infección Asociada a la Asistencia Sanitaria David Cantero González Subdirección de Calidad Organización Central de Osakidetza Infección asociada a la asistencia sanitaria Evento
6. Infecciones nosocomiales
 6. Infecciones nosocomiales La historia de las infecciones nosocomiales (hospitalarias) están antigua como la del hospital; existen infecciones hospitalarias desde el momento en que se agrupan los enfermos
6. Infecciones nosocomiales La historia de las infecciones nosocomiales (hospitalarias) están antigua como la del hospital; existen infecciones hospitalarias desde el momento en que se agrupan los enfermos
NORMA Nº 8 TÉCNICA ASÉPTICA
 GOBIERNO DE CHILE MINISTERIO DE SALUD SUBDEPARTAMENTO DE SALUD VALDIVIA HOSPITAL BASE VALDIVIA Dirección Comité de I.IH. INTRODUCCIÓN: NORMA Nº 8 TÉCNICA ASÉPTICA Las Infecciones Intrahospitalarias son
GOBIERNO DE CHILE MINISTERIO DE SALUD SUBDEPARTAMENTO DE SALUD VALDIVIA HOSPITAL BASE VALDIVIA Dirección Comité de I.IH. INTRODUCCIÓN: NORMA Nº 8 TÉCNICA ASÉPTICA Las Infecciones Intrahospitalarias son
DEPARTAMENTO DE EPIDEMIOLOGÌA
 DEPARTAMENTO DE ENSEÑANZA E INVESTIGACIONES CIENTÌFICAS DEPARTAMENTO DE EPIDEMIOLOGÌA CENTRO DE ENTRENAMIENTO EN EPIDEMIOLOGÌA, PEVENCIÒN Y CONTROL DE INFECCIONES ASOCIADAS A LA ATENCIÒN SANITARIA. El
DEPARTAMENTO DE ENSEÑANZA E INVESTIGACIONES CIENTÌFICAS DEPARTAMENTO DE EPIDEMIOLOGÌA CENTRO DE ENTRENAMIENTO EN EPIDEMIOLOGÌA, PEVENCIÒN Y CONTROL DE INFECCIONES ASOCIADAS A LA ATENCIÒN SANITARIA. El
Transmisión. Contacto Aérea Gotas
 Precauciones Contacto Pascuala Palazón Enfermera UCIH Hospital Morales Meseguer MURCIA Medidas Aislamiento Diseñadas para prevenir la transmisión microorganismos en centros sanitarios. Dirigidas a interrumpir
Precauciones Contacto Pascuala Palazón Enfermera UCIH Hospital Morales Meseguer MURCIA Medidas Aislamiento Diseñadas para prevenir la transmisión microorganismos en centros sanitarios. Dirigidas a interrumpir
Microbiología (Curso )
 Microbiología (Curso 2015-2016) 1. Identificación de la actividad docente La asignatura Microbiología es una asignatura de formación básica del grado en Biología y Medicina. Se imparte en el segundo trimestre
Microbiología (Curso 2015-2016) 1. Identificación de la actividad docente La asignatura Microbiología es una asignatura de formación básica del grado en Biología y Medicina. Se imparte en el segundo trimestre
HIGIENE EN EL MEDIO HOSPITALARIO
 HIGIENE EN EL MEDIO HOSPITALARIO Código Nombre Categoría SN_0079 HIGIENE EN EL MEDIO HOSPITALARIO SANIDAD Duración 30 HORAS Modalidad ONLINE Audio SI Vídeo SI Objetivos OFRECER AL PERSONAL DEL CENTRO SANITARIO
HIGIENE EN EL MEDIO HOSPITALARIO Código Nombre Categoría SN_0079 HIGIENE EN EL MEDIO HOSPITALARIO SANIDAD Duración 30 HORAS Modalidad ONLINE Audio SI Vídeo SI Objetivos OFRECER AL PERSONAL DEL CENTRO SANITARIO
H igiene. del medio hospitalario y limpieza de material
 H igiene del medio hospitalario y limpieza de material Consulte nuestra página web: www.sintesis.com En ella encontrará el catálogo completo y comentado H igiene del medio hospitalario y limpieza de material
H igiene del medio hospitalario y limpieza de material Consulte nuestra página web: www.sintesis.com En ella encontrará el catálogo completo y comentado H igiene del medio hospitalario y limpieza de material
ENFERMEDADES TRANSMITIDAS POR ALIMENTOS ETA. Dirección Vigilancia y Análisis del Riesgo Equipo ETA Abril 2014
 ENFERMEDADES TRANSMITIDAS POR ALIMENTOS ETA Dirección Vigilancia y Análisis del Riesgo Equipo ETA Abril 2014 Contenido Protocolo de vigilancia de ETA Lineamientos de vigilancia y control en salud pública
ENFERMEDADES TRANSMITIDAS POR ALIMENTOS ETA Dirección Vigilancia y Análisis del Riesgo Equipo ETA Abril 2014 Contenido Protocolo de vigilancia de ETA Lineamientos de vigilancia y control en salud pública
1. Conceptos de infectología
 UNIVERSIDAD DE CHILE FACULTAD DE CIENCIAS VETERINARIAS Y PECUARIAS DEPARTAMENTO DE MEDICINA PREVENTIVA 1. Conceptos de infectología Características de los agentes patógenos 1. Conceptos de infectología.
UNIVERSIDAD DE CHILE FACULTAD DE CIENCIAS VETERINARIAS Y PECUARIAS DEPARTAMENTO DE MEDICINA PREVENTIVA 1. Conceptos de infectología Características de los agentes patógenos 1. Conceptos de infectología.
María Espiau Guarner Unitat de Patologia Infecciosa i Immunologia de Pediatria Hospital Vall d Hebron. Barcelona
 Evolución de la enfermedad neumocócica invasora en pediatría: experiencia en nuestro centro María Espiau Guarner Unitat de Patologia Infecciosa i Immunologia de Pediatria Hospital Vall d Hebron. Barcelona
Evolución de la enfermedad neumocócica invasora en pediatría: experiencia en nuestro centro María Espiau Guarner Unitat de Patologia Infecciosa i Immunologia de Pediatria Hospital Vall d Hebron. Barcelona
Microbiología Clínica Interacción con los microorganismos
 Microbiología Clínica 2006-2007 Interacción con los microorganismos MICCLIN2007 Interacción con los microorganismos Concepto de flora normal. Localización de la flora normal. Interacción patogénica entre
Microbiología Clínica 2006-2007 Interacción con los microorganismos MICCLIN2007 Interacción con los microorganismos Concepto de flora normal. Localización de la flora normal. Interacción patogénica entre
INSTRUCCIÓN. Actuación en caso exposición a Varicela
 Página 1 de 6 PAUTAS DE ACTUACIÓN frente a exposición a Definición Este protocolo pretende orientar al trabajador afectado sobre el circuito a seguir en el caso de exposición sin protección con paciente
Página 1 de 6 PAUTAS DE ACTUACIÓN frente a exposición a Definición Este protocolo pretende orientar al trabajador afectado sobre el circuito a seguir en el caso de exposición sin protección con paciente
GUIA Nº2: POSTURA DE GUANTES DE PROCEDIMIENTO Y ESTERILES
 FACULTAD DE ENFERMERÍA ASIGNATURA: CUIDADOS DE ENFERMERÍA EN EL CICLO VITAL I (ENFE-6013) CREADO EQUIPO DOCENTE PAE 1 (2010) ACTUALIZADO EQUIPO DOCENTE CICLO VITAL I (2012-1) TALLER Nº 1 GUIA Nº2: POSTURA
FACULTAD DE ENFERMERÍA ASIGNATURA: CUIDADOS DE ENFERMERÍA EN EL CICLO VITAL I (ENFE-6013) CREADO EQUIPO DOCENTE PAE 1 (2010) ACTUALIZADO EQUIPO DOCENTE CICLO VITAL I (2012-1) TALLER Nº 1 GUIA Nº2: POSTURA
Infección de vías urinarias asociada a sonda vesical
 Infección de vías urinarias asociada a sonda vesical Objetivo: Prevenir el desarrollo de infecciones de vías urinarias relacionadas con la presencia de sonda vesical a permanencia en pacientes hospitalizados,
Infección de vías urinarias asociada a sonda vesical Objetivo: Prevenir el desarrollo de infecciones de vías urinarias relacionadas con la presencia de sonda vesical a permanencia en pacientes hospitalizados,
GUÍA DE APRENDIZAJE. Nombre de la Guía:
 PÁGINA 1 DE 8 FECHA DE ACTUALIZACIÓN: Agosto - 201 1. IDENTIFICACIÓN DE LA GUÍA DE APRENDIZAJE Código Guía: 05-01-01 Nombre de la Guía: Sede Censa: Medellín-Rionegro PREVENCIÓN Y CONTROL DE INFECCIONES
PÁGINA 1 DE 8 FECHA DE ACTUALIZACIÓN: Agosto - 201 1. IDENTIFICACIÓN DE LA GUÍA DE APRENDIZAJE Código Guía: 05-01-01 Nombre de la Guía: Sede Censa: Medellín-Rionegro PREVENCIÓN Y CONTROL DE INFECCIONES
U G C DE MICROBIOLOGÍA. Microbiología Docencia
 U G C DE MICROBIOLOGÍA Microbiología Docencia PLAN DE FORMACION ESPECÍFICO ITINERARIO FORMATIVO ESPECIALIDAD DE MICROBIOLOGIA Y PARASITOLOGIA Programa de formación específico de la especialidad de Microbiología
U G C DE MICROBIOLOGÍA Microbiología Docencia PLAN DE FORMACION ESPECÍFICO ITINERARIO FORMATIVO ESPECIALIDAD DE MICROBIOLOGIA Y PARASITOLOGIA Programa de formación específico de la especialidad de Microbiología
BOLETÍN PUNTO INFORMATIVO EXTRAORDINARIO VIGILANCIA DE LA INFECCIÓN RESPIRATORIA AGUDA GRAVE Y ENFERMEDAD SIMILAR A INFLUENZA
 BOLETÍN PUNTO INFORMATIVO EXTRAORDINARIO VIGILANCIA DE LA INFECCIÓN RESPIRATORIA AGUDA GRAVE Y ENFERMEDAD SIMILAR A INFLUENZA La actividad de Influenza, tanto en Estados Unidos como Canadá, continua siendo
BOLETÍN PUNTO INFORMATIVO EXTRAORDINARIO VIGILANCIA DE LA INFECCIÓN RESPIRATORIA AGUDA GRAVE Y ENFERMEDAD SIMILAR A INFLUENZA La actividad de Influenza, tanto en Estados Unidos como Canadá, continua siendo
5. La infección hospitalaria: herramientas para su control
 5. La infección hospitalaria: herramientas para su control Por definición se considera infección nosocomial o de adquisición hospitalaria a la que no está presente ni se está incubando en el momento del
5. La infección hospitalaria: herramientas para su control Por definición se considera infección nosocomial o de adquisición hospitalaria a la que no está presente ni se está incubando en el momento del
Microbiología Clínica 2006-2007. Dispersión de los microorganismos
 Microbiología Clínica 2006-2007 Dispersión de los microorganismos Dispersión de los microorganismos Tema 6.- Dispersión de los microorganismos. Reservorios y fuentes de infección. El contagio y su prevención.
Microbiología Clínica 2006-2007 Dispersión de los microorganismos Dispersión de los microorganismos Tema 6.- Dispersión de los microorganismos. Reservorios y fuentes de infección. El contagio y su prevención.
CURSO PREVENCION Y CONTROL DE IAAS
 CURSO PREVENCION Y CONTROL DE IAAS DIRECCIÓN DE CAPACITACIÓN Duración: 100 horas cronológicas Dirigido a Profesionales médicos SSAN Introducción La Organización Mundial de la Salud en su documento sobre
CURSO PREVENCION Y CONTROL DE IAAS DIRECCIÓN DE CAPACITACIÓN Duración: 100 horas cronológicas Dirigido a Profesionales médicos SSAN Introducción La Organización Mundial de la Salud en su documento sobre
Salmonelosis no tifoidea y otras infecciones por Samonella
 Salmonelosis no tifoidea y otras infecciones por Samonella Gema Sabrido Bermúdez (R2 pediatría HGUA) Tutora: Mª Carmen Vicent Castello (Adjunto Lactantes) 3 de junio 2015 Índice Salmonella Fiebre tifoidea
Salmonelosis no tifoidea y otras infecciones por Samonella Gema Sabrido Bermúdez (R2 pediatría HGUA) Tutora: Mª Carmen Vicent Castello (Adjunto Lactantes) 3 de junio 2015 Índice Salmonella Fiebre tifoidea
Experiencia Exitosa en la Notificación y Vigilancia activa de las IAAS CLINICA PALERMO
 Experiencia Exitosa en la Notificación y Vigilancia activa de las IAAS CLINICA PALERMO María del Pilar Torres Navarrete Enfermera Epidemiológa Coordinadora de Epidemiología COMITÉ DE INFECCIONES DISTRITAL.
Experiencia Exitosa en la Notificación y Vigilancia activa de las IAAS CLINICA PALERMO María del Pilar Torres Navarrete Enfermera Epidemiológa Coordinadora de Epidemiología COMITÉ DE INFECCIONES DISTRITAL.
Prevención, Diagnóstico y Tratamiento de la Infección de Vías Urinarias No Complicada en Menores de 18 años en el Primero y Segundo Nivel de Atención
 Guía de Referencia Rápida Prevención, Diagnóstico y Tratamiento de la Infección de Vías Urinarias No Complicada en Menores de 18 años en el Primero y Segundo Nivel de Atención Guía de Referencia Rápida
Guía de Referencia Rápida Prevención, Diagnóstico y Tratamiento de la Infección de Vías Urinarias No Complicada en Menores de 18 años en el Primero y Segundo Nivel de Atención Guía de Referencia Rápida
Prevención de Enfermedades Contagiosas
 Prevención de Enfermedades Contagiosas Prevención de Enfermedades Contagiosas - Vacunas La forma mas efectiva de evitar enfermedades contagiosas, cuando lo es posible, son las vacunas. Una vez que la vacuna
Prevención de Enfermedades Contagiosas Prevención de Enfermedades Contagiosas - Vacunas La forma mas efectiva de evitar enfermedades contagiosas, cuando lo es posible, son las vacunas. Una vez que la vacuna
Medidas de prevención de las infecciones emergentes en la comunidad. Teresa Pi-Sunyer Epiech Consulting Barcelona, octubre 2016
 Medidas de prevención de las infecciones emergentes en la comunidad Teresa Pi-Sunyer Epiech Consulting Barcelona, octubre 2016 1. Existe una diferencia real entre las infecciones emergentes y las endémicas?.
Medidas de prevención de las infecciones emergentes en la comunidad Teresa Pi-Sunyer Epiech Consulting Barcelona, octubre 2016 1. Existe una diferencia real entre las infecciones emergentes y las endémicas?.
SISTEMA DE VIGILANCIA DE LAS IIH - IAAS en Hospital Dr. Rafael Avaria Valenzuela de Curanilahue
 SISTEMA DE VIGILANCIA DE LAS IIH - IAAS en Hospital Dr. Rafael Avaria Valenzuela de Curanilahue Resolución N : 0454 del 20/04/2012 Página 1 de 25 Indice INTRODUCCIÓN... 3 PROPÓSITO... 3 OBJETIVOS... 3
SISTEMA DE VIGILANCIA DE LAS IIH - IAAS en Hospital Dr. Rafael Avaria Valenzuela de Curanilahue Resolución N : 0454 del 20/04/2012 Página 1 de 25 Indice INTRODUCCIÓN... 3 PROPÓSITO... 3 OBJETIVOS... 3
Brotes de Infección Intrahospitalaria en Servicios de Neonatología: Brotes por Serratia Marcescens. Marzo 2015
 Brotes de Infección Intrahospitalaria en Servicios de Neonatología: Brotes por Serratia Marcescens Marzo 2015 DEFINICIÓN DE BROTE Aumento inusual, por encima del nivel esperado, de la incidencia de determinada
Brotes de Infección Intrahospitalaria en Servicios de Neonatología: Brotes por Serratia Marcescens Marzo 2015 DEFINICIÓN DE BROTE Aumento inusual, por encima del nivel esperado, de la incidencia de determinada
INDICACIONES PARA LA HIGIENE DE MANOS
 Medicina Preventiva y Salud Pública H.C.U.V. Actualizado 2010 INDICACIONES PARA LA HIGIENE DE MANOS Debe realizarse higiene de las manos por parte del personal sanitario en las siguientes situaciones A.
Medicina Preventiva y Salud Pública H.C.U.V. Actualizado 2010 INDICACIONES PARA LA HIGIENE DE MANOS Debe realizarse higiene de las manos por parte del personal sanitario en las siguientes situaciones A.
TEMA 3 EL DIAGNÓSTICO MICROBIOLÓGICO
 TEMA 3 EL DIAGNÓSTICO MICROBIOLÓGICO FUNDAMENTOS DEL DIAGNÓSTICO DE LAS INFECCIONES DE VIAS URINARIAS METODOLOGÍA UTILIZADA PARA EL DIAGNÓSTICO DE INFECCION URINARIA DIAGNÓSTICO MICROBIOLÓGICO DIAGNOSTICO
TEMA 3 EL DIAGNÓSTICO MICROBIOLÓGICO FUNDAMENTOS DEL DIAGNÓSTICO DE LAS INFECCIONES DE VIAS URINARIAS METODOLOGÍA UTILIZADA PARA EL DIAGNÓSTICO DE INFECCION URINARIA DIAGNÓSTICO MICROBIOLÓGICO DIAGNOSTICO
2. Precauciones de Rutina para el Control de Infecciones de Enfermedades Respiratorias
 2. PRECAUCIONES DE RUTINA PARA EL CONTROL DE INFECCIONES DE ENFERMEDADES RESPIRATORIAS 2. Precauciones de Rutina para el Control de Infecciones de Enfermedades Respiratorias Precauciones estándar Las precauciones
2. PRECAUCIONES DE RUTINA PARA EL CONTROL DE INFECCIONES DE ENFERMEDADES RESPIRATORIAS 2. Precauciones de Rutina para el Control de Infecciones de Enfermedades Respiratorias Precauciones estándar Las precauciones
Curriculum vitae resumido. Domicilio profesional: Hospital de Niños Dr. Ricardo Gutiérrez. Buenos Aires. Argentina
 Curriculum vitae resumido Datos de Filiación Nombre y Apellido: María del Pilar Arias López Fecha de nacimiento: 2-11-1966 DNI 17933240 Domicilio profesional: Hospital de Niños Dr. Ricardo Gutiérrez. Buenos
Curriculum vitae resumido Datos de Filiación Nombre y Apellido: María del Pilar Arias López Fecha de nacimiento: 2-11-1966 DNI 17933240 Domicilio profesional: Hospital de Niños Dr. Ricardo Gutiérrez. Buenos
Norma/Política Precauciones, estándares y uso adecuado de desinfectantes
 01.00 de / Modificación: 01/00 Fecha de Vigencia: 27/12/13 Responsable de Gestión de la norma/política: Dra. Inés Staneloni/ Int. 8165 Mail: [email protected] Estándar: PCI.9 Referencias:
01.00 de / Modificación: 01/00 Fecha de Vigencia: 27/12/13 Responsable de Gestión de la norma/política: Dra. Inés Staneloni/ Int. 8165 Mail: [email protected] Estándar: PCI.9 Referencias:
LABORATORIO DE Biología Molecular. Responsable: Microbiólogo Victor Juan Zea Gutierrez
 LABORATORIO DE Biología Molecular Responsable: Microbiólogo Victor Juan Zea Gutierrez El Laboratorio de biología molecular tiene por objetivo principal, el ofrecer una infraestructura completa, altamente
LABORATORIO DE Biología Molecular Responsable: Microbiólogo Victor Juan Zea Gutierrez El Laboratorio de biología molecular tiene por objetivo principal, el ofrecer una infraestructura completa, altamente
NORMA DE AISLAMIENTO Y PRECAUCIONES ESTÁNDAR
 GOBIERNO DE CHILE MINISTERIO DE SALUD HOSPITAL DEL SALVADOR OFICINA DE CALIDAD Y SEGURIDAD DEL PACIENTE NORMA DE AISLAMIENTO Y PRECAUCIONES ESTÁNDAR Página 1 de 12 INDICE TEMA PAGINA Capitulo I Introducción---------------------------------------------------------
GOBIERNO DE CHILE MINISTERIO DE SALUD HOSPITAL DEL SALVADOR OFICINA DE CALIDAD Y SEGURIDAD DEL PACIENTE NORMA DE AISLAMIENTO Y PRECAUCIONES ESTÁNDAR Página 1 de 12 INDICE TEMA PAGINA Capitulo I Introducción---------------------------------------------------------
Toma de Muestras Microbiológicas
 Toma de Muestras Microbiológicas MICROBIOLOGÍA CLÍNICA DIAGNÓSTICO DE ENFERMEDADES INFECCIOSAS MUESTRA AISLAMIENTO IDENTIFICACIÓN SENSIBILIDAD A ANTIMICROBIANOS Detección de anticuerpos, antígenos y ácidos
Toma de Muestras Microbiológicas MICROBIOLOGÍA CLÍNICA DIAGNÓSTICO DE ENFERMEDADES INFECCIOSAS MUESTRA AISLAMIENTO IDENTIFICACIÓN SENSIBILIDAD A ANTIMICROBIANOS Detección de anticuerpos, antígenos y ácidos
INFECCIÓN DEL TRACTO URINARIO e IAAS. Prevención y diagnostico Dra. Dona Benadof F
 INFECCIÓN DEL TRACTO URINARIO e IAAS Prevención y diagnostico Dra. Dona Benadof F Objetivos Al término de esta presentación podrá: Entender la importancia clínica de la infección urinaria Identificar los
INFECCIÓN DEL TRACTO URINARIO e IAAS Prevención y diagnostico Dra. Dona Benadof F Objetivos Al término de esta presentación podrá: Entender la importancia clínica de la infección urinaria Identificar los
EPIDEMIOLOGÍA y PROFILAXIS DE LAS ENFERMEDADES INFECCIOSAS
 EPIDEMIOLOGÍA y PROFILAXIS DE LAS ENFERMEDADES INFECCIOSAS EPIDEMIOLOGÍA Enfermedades y Problemas de Salud en la comunidad, para Conocer los Factores que determinan Frecuencia grupos de población. Distribución
EPIDEMIOLOGÍA y PROFILAXIS DE LAS ENFERMEDADES INFECCIOSAS EPIDEMIOLOGÍA Enfermedades y Problemas de Salud en la comunidad, para Conocer los Factores que determinan Frecuencia grupos de población. Distribución
MÓDULO: HIGIENE DEL MEDIO HOSPITALARIO OBJETIVOS
 IES Diego de Guzmán y Quesada Documento: Resumen de programación Nº de documento Revisión: Página 1 CURSO 2011/2012 MÓDULO: HIGIENE DEL MEDIO HOSPITALARIO OBJETIVOS DEPARTAMENTO SANITARIA CURSO 1º CAE
IES Diego de Guzmán y Quesada Documento: Resumen de programación Nº de documento Revisión: Página 1 CURSO 2011/2012 MÓDULO: HIGIENE DEL MEDIO HOSPITALARIO OBJETIVOS DEPARTAMENTO SANITARIA CURSO 1º CAE
SOCIEDAD VENEZOLANA DE BIOANALISTAS ESPECIALISTAS PROGRAMA DIPLOMADO BACTERIOLOGÍA CLÍNICA" (II Edición: Mayo-Agosto 2013) OBJETIVO DURACIÓN
PROGRAMA DIPLOMADO BACTERIOLOGÍA CLÍNICA" (II Edición: Mayo-Agosto 2013) OBJETIVO El objetivo de este Diplomado es profundizar en tópicos de interés en la práctica diaria de la Bacteriología Clínica, proporcionando
PROGRAMA DIPLOMADO BACTERIOLOGÍA CLÍNICA" (II Edición: Mayo-Agosto 2013) OBJETIVO El objetivo de este Diplomado es profundizar en tópicos de interés en la práctica diaria de la Bacteriología Clínica, proporcionando
MANUAL DE GUÍAS CLÍNICAS DE ABORDAJE DE LA FIEBRE EN EL PACIENTE HOSPITALIZADO
 Fecha: JUN 15 Hoja: 1 de 5 MANUAL DE GUÍAS CLÍNICAS DE ABORDAJE DE LA FIEBRE EN EL PACIENTE HOSPITALIZADO Elaboró: Revisó: Autorizó: Puesto Médico Infectólogo Director Quirúrgico Director Quirúrgico Firma
Fecha: JUN 15 Hoja: 1 de 5 MANUAL DE GUÍAS CLÍNICAS DE ABORDAJE DE LA FIEBRE EN EL PACIENTE HOSPITALIZADO Elaboró: Revisó: Autorizó: Puesto Médico Infectólogo Director Quirúrgico Director Quirúrgico Firma
Validación del proceso de desinfección
 Validación del proceso de desinfección Silvia I. Acosta-Gnass Prevención y Control de Infecciones Riverside County Regional Medical Center Moreno Valley, California, EEUU Pan American Health Organization
Validación del proceso de desinfección Silvia I. Acosta-Gnass Prevención y Control de Infecciones Riverside County Regional Medical Center Moreno Valley, California, EEUU Pan American Health Organization
EPINE: EVOLUCIÓN , CON RESUMEN DE 2014
 EPINE: EVOLUCIÓN 1990-2014, CON RESUMEN DE 2014 Hospitales incluidos. EPINE 1990-2014 Número de Hospitales 300 250 258 257 253 266 276 278 287 287 271 282 269 200 201 206 214 224 233 243 243 246 241 186
EPINE: EVOLUCIÓN 1990-2014, CON RESUMEN DE 2014 Hospitales incluidos. EPINE 1990-2014 Número de Hospitales 300 250 258 257 253 266 276 278 287 287 271 282 269 200 201 206 214 224 233 243 243 246 241 186
Agente infeccioso emergente de difícil diagnóstico clínico y morfológico
 Agente infeccioso emergente de difícil diagnóstico clínico y morfológico Especies de importancia en medicina humana: Naegleria fowlerii Balamutia mandrilaris Acanthamoeba spp Ciclo de vida trofozoito quiste
Agente infeccioso emergente de difícil diagnóstico clínico y morfológico Especies de importancia en medicina humana: Naegleria fowlerii Balamutia mandrilaris Acanthamoeba spp Ciclo de vida trofozoito quiste
FACULTAD DE TECNOLOGÍA DE LA SALUD Dr. SALVADOR ALLENDE HIGIENE Y EPIDEMIOLOGIA LICENCIATURA EN TECNOLOGÍA DE LA SALUD.
 FAULTAD DE TENOLOGÍA DE LA SALUD Dr. SALVADOR ALLENDE HIGIENE Y EPIDEMIOLOGIA LIENIATURA EN TENOLOGÍA DE LA SALUD. PI URSO 2005-2006 ENTRO DE EDUAIÓN SUPERIOR PLAN ALENDARIO DE LA ASIGNATURA ( P1 ) ISM
FAULTAD DE TENOLOGÍA DE LA SALUD Dr. SALVADOR ALLENDE HIGIENE Y EPIDEMIOLOGIA LIENIATURA EN TENOLOGÍA DE LA SALUD. PI URSO 2005-2006 ENTRO DE EDUAIÓN SUPERIOR PLAN ALENDARIO DE LA ASIGNATURA ( P1 ) ISM
UNIDAD DIDÁCTICA III: INFECCIONES ASOCIADAS A LA ATENCIÓN SANITARIA
 UNIDAD DIDÁCTICA III: INFECCIONES ASOCIADAS A LA ATENCIÓN SANITARIA Apartados de información del Unidad Didáctica III De qué estamos hablando cuando decimos infecciones asociadas a la atención sanitaria?
UNIDAD DIDÁCTICA III: INFECCIONES ASOCIADAS A LA ATENCIÓN SANITARIA Apartados de información del Unidad Didáctica III De qué estamos hablando cuando decimos infecciones asociadas a la atención sanitaria?
CAPACITACIÓN EN INFECCIONES ASOCIADAS A LA ATENCIÓN DE SALUD (I.A.A.S.) HOSPITAL DE CAUQUENES AÑO 2012
 1 CAPACITACIÓN EN INFECCIONES ASOCIADAS A LA ATENCIÓN DE SALUD (I.A.A.S.) HOSPITAL DE CAUQUENES AÑO 2012 2 INDICE 1. Introducción: 03 2. Alcance 03 3. Objetivo General.....04 4. Objetivos Específicos.04
1 CAPACITACIÓN EN INFECCIONES ASOCIADAS A LA ATENCIÓN DE SALUD (I.A.A.S.) HOSPITAL DE CAUQUENES AÑO 2012 2 INDICE 1. Introducción: 03 2. Alcance 03 3. Objetivo General.....04 4. Objetivos Específicos.04
PROGRAMA de asignaturas
 27036 MICROBIOLOGÍA Y PARASITOLOGÍA Curso Académico 2007-2008 Núm.Créditos Totales 6 Núm.Créditos Teóricos 5 Núm.Créditos Prácticos 1 Curso 1º Semestre 2º Tipo (T, O, OP, L.E) T PROGRAMA de asignaturas
27036 MICROBIOLOGÍA Y PARASITOLOGÍA Curso Académico 2007-2008 Núm.Créditos Totales 6 Núm.Créditos Teóricos 5 Núm.Créditos Prácticos 1 Curso 1º Semestre 2º Tipo (T, O, OP, L.E) T PROGRAMA de asignaturas
ESTUDIO BACTERIOLÓGICO DE TEJIDO PERI-APICAL RELACIONADO CON INFECCIONES SEVERAS Y SENSIBILIDAD ANTIBIÓTICA (ESTUDIO PRELIMINAR)
 UNIVERSIDAD DE BUENOS AIRES FACULTAD DE ODONTOLOGÍA ESTUDIO BACTERIOLÓGICO DE TEJIDO PERI-APICAL RELACIONADO CON INFECCIONES SEVERAS Y SENSIBILIDAD ANTIBIÓTICA (ESTUDIO PRELIMINAR) PABLO RODRIGUEZ JAVIER
UNIVERSIDAD DE BUENOS AIRES FACULTAD DE ODONTOLOGÍA ESTUDIO BACTERIOLÓGICO DE TEJIDO PERI-APICAL RELACIONADO CON INFECCIONES SEVERAS Y SENSIBILIDAD ANTIBIÓTICA (ESTUDIO PRELIMINAR) PABLO RODRIGUEZ JAVIER
HPAI - Influenza aviar altamente patógena
 Influenza Aviar (AI) HPAI - Influenza aviar altamente patógena Lista A de la OIE (Enfermedad de declaración obligatoria) Directiva 92/40/CEE del Consejo Real decreto 1025/1993 BOE num.240 LPAI - Influenza
Influenza Aviar (AI) HPAI - Influenza aviar altamente patógena Lista A de la OIE (Enfermedad de declaración obligatoria) Directiva 92/40/CEE del Consejo Real decreto 1025/1993 BOE num.240 LPAI - Influenza
INFECCIONES RELACIONADAS A TERAPIA INTRAVENOSA. Alethse De la Torre
 INFECCIONES RELACIONADAS A TERAPIA INTRAVENOSA Alethse De la Torre Primum Non Nocere Qué tan inseguro es un Hospital? Muertes por 100 millones horas Embarazo 1 Viajar por tren 5 Trabajar en casa 8 Agricultura
INFECCIONES RELACIONADAS A TERAPIA INTRAVENOSA Alethse De la Torre Primum Non Nocere Qué tan inseguro es un Hospital? Muertes por 100 millones horas Embarazo 1 Viajar por tren 5 Trabajar en casa 8 Agricultura
Evolución de la Jurisprudencia en las reclamaciones por Infección relacionada con la Asistencia Sanitaria.
 Evolución de la Jurisprudencia en las reclamaciones por Infección relacionada con la Asistencia Sanitaria. Por Ignacio Megía Dtor. Siniestros y Ases. Jurídica de W.R. Berkley España 1 Planteamiento Analizamos
Evolución de la Jurisprudencia en las reclamaciones por Infección relacionada con la Asistencia Sanitaria. Por Ignacio Megía Dtor. Siniestros y Ases. Jurídica de W.R. Berkley España 1 Planteamiento Analizamos
Plan Nacional para reducir el riesgo de selección y diseminación de resistencia a los antibióticos
 Plan Nacional para reducir el riesgo de selección y diseminación de resistencia a los antibióticos Cristina Muñoz Madero Asamblea general de Prioridad de salud pública política El Plan de Acción Dónde
Plan Nacional para reducir el riesgo de selección y diseminación de resistencia a los antibióticos Cristina Muñoz Madero Asamblea general de Prioridad de salud pública política El Plan de Acción Dónde
INFLUENZA HUMANA A- H1N1
 INFLUENZA HUMANA A- H1N1 INFLUENZA ESTACIONAL QUÉ ES? Infección aguda que resulta de la infección con el virus de influenza. Nos afecta todos los años en otoño e invierno. Existen grupos de personas más
INFLUENZA HUMANA A- H1N1 INFLUENZA ESTACIONAL QUÉ ES? Infección aguda que resulta de la infección con el virus de influenza. Nos afecta todos los años en otoño e invierno. Existen grupos de personas más
ANTIBIOTICOS. Futuro de su utilización en la producción industrial. Miguel Ángel HIGUERA Director ANPROGAPOR
 ANTIBIOTICOS. Futuro de su utilización en la producción industrial Miguel Ángel HIGUERA Director ANPROGAPOR Enfermedad Libre de enfermedad? (utópico) Bioseguridad Profilaxis (Metafilaxis) Terapia Antibióticos
ANTIBIOTICOS. Futuro de su utilización en la producción industrial Miguel Ángel HIGUERA Director ANPROGAPOR Enfermedad Libre de enfermedad? (utópico) Bioseguridad Profilaxis (Metafilaxis) Terapia Antibióticos
Vigilancia Epidemiológica
 Vigilancia Epidemiológica Lic. María Andrea Vargas Huapaya Especialista en Epidemiología de Campo Definición de Epidemiología Definición de Vigilancia Epidemiología Es un proceso continuo y sistemático
Vigilancia Epidemiológica Lic. María Andrea Vargas Huapaya Especialista en Epidemiología de Campo Definición de Epidemiología Definición de Vigilancia Epidemiología Es un proceso continuo y sistemático
AISLAMIENTOS : Actuación TCE en el área de Urgencias
 AISLAMIENTOS : Actuación TCE en el área de Urgencias AGENTES INFECCIOSOS VIRUS (Gripe a H1N1) BACTERIAS (Bacilo de Koch) PARASITOS (Piojos) PATOLOGIAS MAS FRECUENTES CONTACTO: Transmisión por contacto
AISLAMIENTOS : Actuación TCE en el área de Urgencias AGENTES INFECCIOSOS VIRUS (Gripe a H1N1) BACTERIAS (Bacilo de Koch) PARASITOS (Piojos) PATOLOGIAS MAS FRECUENTES CONTACTO: Transmisión por contacto
PORQUE NO NOS LAVAMOS LAS MANOS? Edwin Silva Monsalve MD. Infectólogo HOMIC CPO
 PORQUE NO NOS LAVAMOS LAS MANOS? Edwin Silva Monsalve MD. Infectólogo HOMIC CPO TENDENCIA DE A baumannii RESISTENTE A IMIPENEM 90 80 70 60 50 40 30 NO UCI UCI 20 10 0 Ene-01 Abr-01 Jul-01 Oct-01 Ene-02
PORQUE NO NOS LAVAMOS LAS MANOS? Edwin Silva Monsalve MD. Infectólogo HOMIC CPO TENDENCIA DE A baumannii RESISTENTE A IMIPENEM 90 80 70 60 50 40 30 NO UCI UCI 20 10 0 Ene-01 Abr-01 Jul-01 Oct-01 Ene-02
BIOSEGURIDAD. Dirección de Vigilancia y Análisis del Riesgo en Salud Pública
 BIOSEGURIDAD Dirección de Vigilancia y Análisis del Riesgo en Salud Pública Bioseguridad Conjunto de medidas universales destinadas a proteger al personal, la comunidad y el medio ambiente de riesgos a
BIOSEGURIDAD Dirección de Vigilancia y Análisis del Riesgo en Salud Pública Bioseguridad Conjunto de medidas universales destinadas a proteger al personal, la comunidad y el medio ambiente de riesgos a
UNIVERSIDAD MARÍA AUXILIADORA - UMA
 SÍLABO DE MICROBIOLOGÍA I.- DATOS GENERALES 1.1. Escuela Profesional 1.2. Semestre Académico 1.3. Ciclo 1.4. Pre requisitos 1.5. Créditos 1.6. Duración 1.7. Códigos : Farmacia y Bioquímica : 2015 II :
SÍLABO DE MICROBIOLOGÍA I.- DATOS GENERALES 1.1. Escuela Profesional 1.2. Semestre Académico 1.3. Ciclo 1.4. Pre requisitos 1.5. Créditos 1.6. Duración 1.7. Códigos : Farmacia y Bioquímica : 2015 II :
Infecciones Asociadas a la Atención en Salud (IAAS) Alicia Elgueta G EU IAAS
 Infecciones Asociadas a la Atención en Salud (IAAS) Alicia Elgueta G EU IAAS Objetivos Al término de la presentación ustedes podrán: Analizar concepto IAAS Identificar a las IAAS como problema de salud
Infecciones Asociadas a la Atención en Salud (IAAS) Alicia Elgueta G EU IAAS Objetivos Al término de la presentación ustedes podrán: Analizar concepto IAAS Identificar a las IAAS como problema de salud
Cefalosporinas Indicaciones y Contraindicaciones
 Cefalosporinas Indicaciones y Contraindicaciones Dra. Ma. Consuelo Rojas Cefalosporinas Sustancias químicas producidas por una especie de hongo cephalosporium acremonium. Son betalactámicos Químicamente
Cefalosporinas Indicaciones y Contraindicaciones Dra. Ma. Consuelo Rojas Cefalosporinas Sustancias químicas producidas por una especie de hongo cephalosporium acremonium. Son betalactámicos Químicamente
Actuaciones en Infección en herida quirúrgica. Carmen Lupión Mendoza Enfermera de Control de Infecciones Hospital Universitario Virgen Macarena
 Actuaciones en Infección en herida quirúrgica Carmen Lupión Mendoza Enfermera de Control de Infecciones Hospital Universitario Virgen Macarena Análisis de los datos 3.48 Análisis de los datos 10.86 Análisis
Actuaciones en Infección en herida quirúrgica Carmen Lupión Mendoza Enfermera de Control de Infecciones Hospital Universitario Virgen Macarena Análisis de los datos 3.48 Análisis de los datos 10.86 Análisis
Infección respiratoria aguda
 Infección respiratoria aguda Carlos Andrés Agudelo. MD, MSc Infectólogo - Epidemiólogo Clínica Universitaria Bolivariana Universidad Pontificia Bolivariana Centros Especializados de San Vicente Fundación
Infección respiratoria aguda Carlos Andrés Agudelo. MD, MSc Infectólogo - Epidemiólogo Clínica Universitaria Bolivariana Universidad Pontificia Bolivariana Centros Especializados de San Vicente Fundación
Guía Docente: Guía Básica. Datos para la identificación de la asignatura. Facultad de Ciencias de la Salud
 Guía Docente: Guía Básica Datos para la identificación de la asignatura. CENTRO: Facultad de Ciencias de la Salud TITULACIÓN: Medicina Enfermedades del Aparato Digestivo CÓDIGO ULPGC 42928 CÓDIGOS UNESCO
Guía Docente: Guía Básica Datos para la identificación de la asignatura. CENTRO: Facultad de Ciencias de la Salud TITULACIÓN: Medicina Enfermedades del Aparato Digestivo CÓDIGO ULPGC 42928 CÓDIGOS UNESCO
HOSPITAL NACIONAL SERGIO E. BERNALES
 Enero Marzo 2011 HOSPITAL NACIONAL SERGIO E. BERNALES Jefatura de la Oficina de Epidemiología y Salud Ambiental DIAGNOSTICO SITUACIONAL DE LAS INFECCIONES INTRAHOSPITALARIAS 1 Análisis estadístico y epidemiológico
Enero Marzo 2011 HOSPITAL NACIONAL SERGIO E. BERNALES Jefatura de la Oficina de Epidemiología y Salud Ambiental DIAGNOSTICO SITUACIONAL DE LAS INFECCIONES INTRAHOSPITALARIAS 1 Análisis estadístico y epidemiológico
Hay que aislar a los Gram negativos multir? : Cual, cómo y hasta cuando
 Hay que aislar a los Gram negativos multir? : Cual, cómo y hasta cuando Cristina González Juanes Programa Control de Infecciones. Servicio de Epidemiología y Evaluación. Reunión XVI GEIH.Sevilla 2010 Introducción
Hay que aislar a los Gram negativos multir? : Cual, cómo y hasta cuando Cristina González Juanes Programa Control de Infecciones. Servicio de Epidemiología y Evaluación. Reunión XVI GEIH.Sevilla 2010 Introducción
Prevención de infecciones asociadas a catéteres vasculares y sondas urinarias: de la teoría a la práctica.
 Jesús Rodríguez Baño Prevención de infecciones asociadas a catéteres vasculares y sondas urinarias: de la teoría a la práctica. www.aulascience.es Unidad didáctica 1 Etiología y epidemiología de la infección
Jesús Rodríguez Baño Prevención de infecciones asociadas a catéteres vasculares y sondas urinarias: de la teoría a la práctica. www.aulascience.es Unidad didáctica 1 Etiología y epidemiología de la infección
PROTOCOLO DE ENFERMERÍA PARA HIGIENIZACIÓN DE MANOS
 Revisó Jefe DBU / Jefe SSISDP Aprobó: Rector Página 1 de 7 Fecha de aprobación: Agosto 05 de 2014 Resolución N 1504 1. OBJETIVO Establecer los lineamientos para prevenir la transmisión de infecciones cruzadas
Revisó Jefe DBU / Jefe SSISDP Aprobó: Rector Página 1 de 7 Fecha de aprobación: Agosto 05 de 2014 Resolución N 1504 1. OBJETIVO Establecer los lineamientos para prevenir la transmisión de infecciones cruzadas
"Recomendaciones de tratamiento antiviral en infecciones respiratorias bajas 2010"
 "Recomendaciones de tratamiento antiviral en infecciones respiratorias bajas 2010" 14 de junio de 2010 Comités Nacionales de Infectología y Pediatría Ambulatoria Sociedad Argentina de Pediatría Enfermedad
"Recomendaciones de tratamiento antiviral en infecciones respiratorias bajas 2010" 14 de junio de 2010 Comités Nacionales de Infectología y Pediatría Ambulatoria Sociedad Argentina de Pediatría Enfermedad
Prevención y Tratamientos
 Enfermedades Respiratorias Prevención y Tratamientos (Vacuna Antigripal y Kinesiterapia Respiratoria) www.clinicaalemanaosorno.cl Enfermedades respiratorias agudas Son enfermedades infecciosas (virales
Enfermedades Respiratorias Prevención y Tratamientos (Vacuna Antigripal y Kinesiterapia Respiratoria) www.clinicaalemanaosorno.cl Enfermedades respiratorias agudas Son enfermedades infecciosas (virales
TITULACIÓN: GRADO EN BIOLOGÍA CENTRO: FACULTAD DE CIENCIAS EXPERIMENTALES CURSO ACADÉMICO: GUÍA DOCENTE
 TITULACIÓN: GRADO EN BIOLOGÍA CENTRO: FACULTAD DE CIENCIAS EXPERIMENTALES CURSO ACADÉMICO: 2011-2012 GUÍA DOCENTE 1. DATOS BÁSICOS DE LA ASIGNATURA NOMBRE: MICROBIOLOGÍA CLÍNICA CÓDIGO: 10213007 CURSO
TITULACIÓN: GRADO EN BIOLOGÍA CENTRO: FACULTAD DE CIENCIAS EXPERIMENTALES CURSO ACADÉMICO: 2011-2012 GUÍA DOCENTE 1. DATOS BÁSICOS DE LA ASIGNATURA NOMBRE: MICROBIOLOGÍA CLÍNICA CÓDIGO: 10213007 CURSO
Peste Porcina. Qué es la Peste Porcina?
 Peste Porcina Qué es la Peste Porcina? Enfermedad infectocontagiosa que afecta exclusivamente al ganado porcino, y cerdos salvajes de todas las edades, producida por un virus de carácter hemorrágico que
Peste Porcina Qué es la Peste Porcina? Enfermedad infectocontagiosa que afecta exclusivamente al ganado porcino, y cerdos salvajes de todas las edades, producida por un virus de carácter hemorrágico que

 Additional details >>> HERE
Additional details >>> HERE